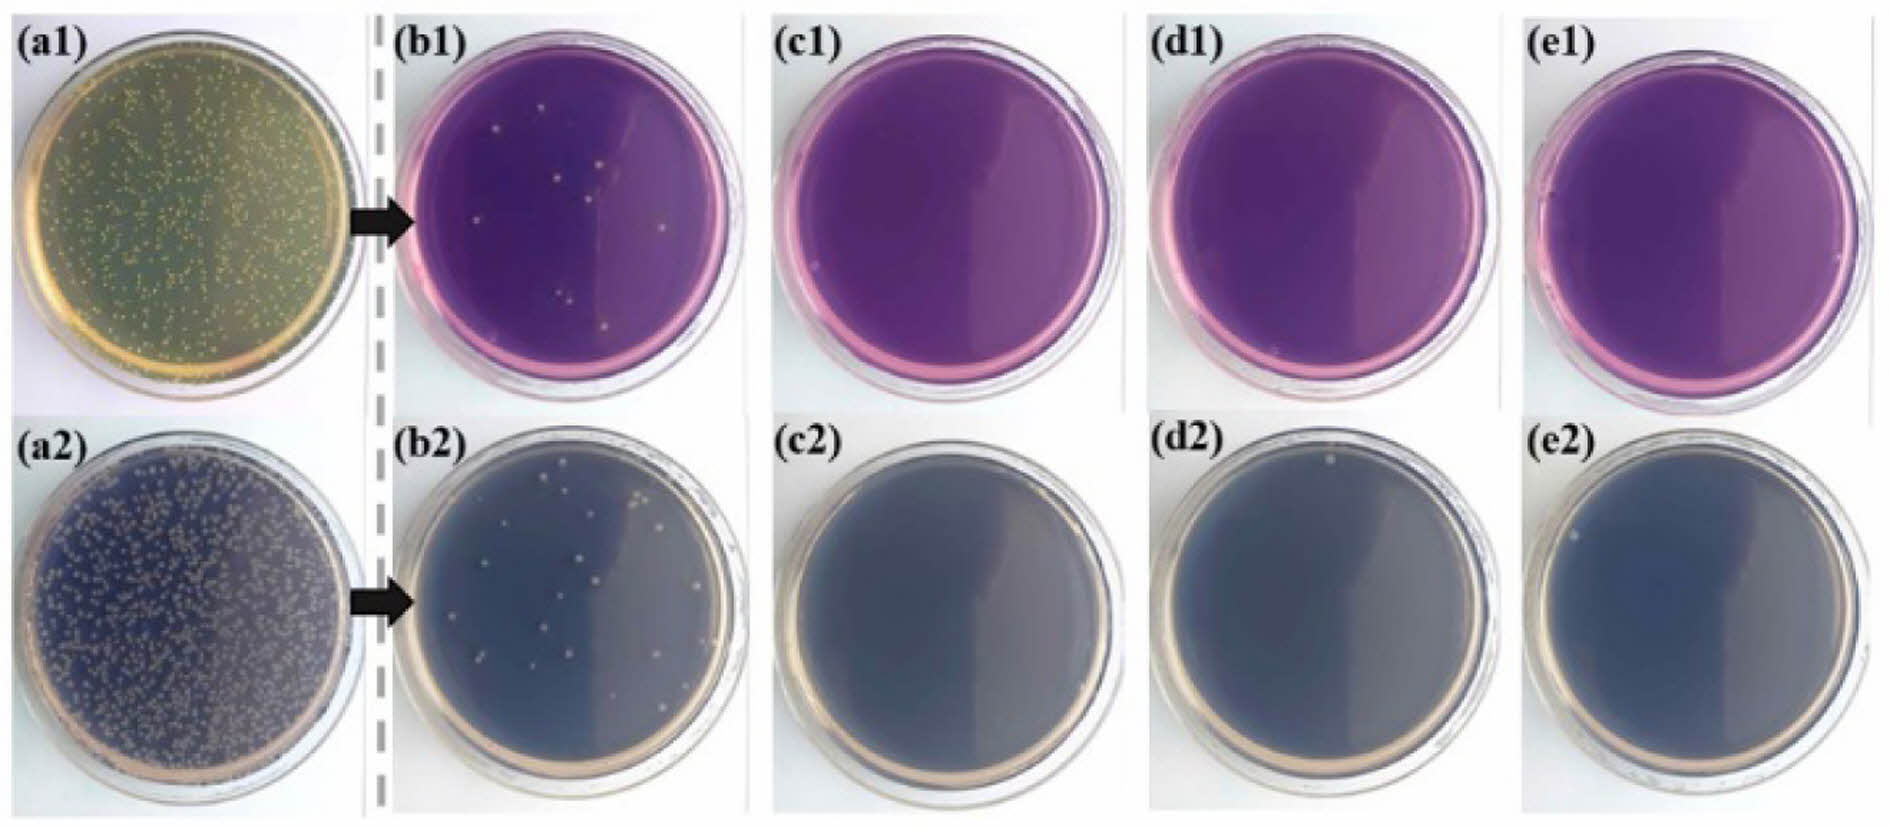

- Antimicrobial Property of Polydimethylsiloxane Film Coated with Aminosilanes
Yeji Park, Sumin Jeong, Md Shahjahan Kabir Chowdury, SungBum Park*, and Yong-il Park†

School of Materials Science and Engineering, Kumoh National Institute of Technology, 61 Daehak-ro, Gumi, Gyeongbuk 39177, Korea
*Department of Automotive Materials and Components Engineering, Dongguk University WISE Campus, Gyeongju 38066, Korea- 아미노실란을코팅한폴리디메틸실록산필름의항균특성
국립금오공과대학교 신소재공학과, *동국대학교 WISE캠퍼스 자동차소재부품공학과
Reproduction, stored in a retrieval system, or transmitted in any form of any part of this publication is permitted only by written permission from the Polymer Society of Korea.
Due to the global pandemic of Covid-19, various studies are being conducted to overcome it. In the case of existing antibacterial plastics, a simple method of mixing various antibacterial agents into a polymer is used, but this has the disadvantage that the antibacterial activity gradually decreases as they are eluted from the polymer over time. To solve this problem, research is underway to chemically bond antibacterial functional groups to the polymer chains that make up the matrix. Antibacterial functional groups such as cations kill bacteria by disrupting or destroying the anionic cell membrane of bacteria, or causing metabolic disorders after diffusing into cells. In this work, we used a method to arrange an organic-inorganic complex aminosilane thin layer on the surface of polydimethylsiloxane (PDMS) film at a high concentration to maintain and maximize the antimicrobial activity. By bonding the hydrophilic alkoxy functional group to the substrate side, it is possible to orient the amine functional group toward the surface, thereby maximizing antibacterial properties. As a result, aminosilane hybrid coating layers showed excellent antibacterial activities and so we could solve the durability problem of the conventional antimicrobial plastics.
Covid-19의 전세계적 대유행에 따라 그 극복을 위한 다양한 연구가 진행되고 있다. 기존의 항균 플라스틱의 경우, 여러가지 항균제를 고분자에 혼합하는 단순한 방법을 사용하는데, 시간에 따라 고분자로부터 용출되어 항균력이 점차 감소하게 되는 단점이 있다. 이를 해결하는 방법으로 매트릭스를 이루는 고분자 사슬에 항균성 작용기를 화학 결합시키는 연구가 진행되고 있다. 양이온을 함유하는 항균성 작용기는 음이온성인 세균의 세포막을 교란 또는 파괴하거나, 세포 안으로 확산해 들어가 대사장애를 일으킴으로써 세균을 사멸시킨다. 본 연구에서는 항균성 작용기의 항균력의 지속과 이의 극대화를 위해 polydimethylsiloxane(PDMS) 필름 표면에 유-무기 복합성 아미노실란 박막을 고밀도로 배열시키는 방법을 사용하였다. 특히 친수성 알콕시 작용기가 기판측과 결합함으로써 아민 작용기가 표면 측으로 배향시키는 것이 가능하며, 이로써 항균성의 극대화가 가능하였다. 결과적으로, 아미노실란 하이브리드 코팅층이 우수한 항균력을 보였으며 이로써 기존 항균 플라스틱의 지속성 문제를 해결할 수 있게 되었다.
In this work, we used a method to arrange an organic-inorganic complex aminosilane thin layer on the surface of polydimethylsiloxane (PDMS) film at a high concentration to maintain and maximize the antimicrobial activity. All three types of amino-silane coated films showed a high antibacterial activity with a bacterial reduction rate of 99.9% against Staphylococcus aureus (ATCC 6538P) and Escherichia coli (ATCC 8739).

Keywords: biopolymers, coating materials, (3-aminopropyl)triethoxysilane, 3-aminopropyl(diethoxy)methylsilane, aminopropyldimethylethoxysilane, antimicrobial activity, polydimethylsiloxane.
이 연구는 금오공과대학교 대학 학술연구비로 지원되었음(2023).
저자들은 이해상충이 없음을 선언합니다.
다음과 관련된 실험 과정에 대한 정보(EDS mapping results, thickness measurements). 이 자료는 다음 사이트에서 얻을 수 있습니다(http://journal.polymer-korea.or.kr).
PK_2024_048_03_274_Supporting_Information.pdf (1041 kb)
Supplementary Information
Covid-19의 전 세계적 대유행에 따라 손 소독제와 같은 항균성을 지닌 제품의 사용이 일상화가 되고 있다. 또한 엘리베이터와 같은 다중이용시설물의 표면 오염을 통한 전파를 최소화하기 위해 항균 특성을 갖는 구리 이온 필름의 사용이 늘고 있으며, 바이러스 및 박테리아의 억제는 사람들에게 개인 위
생과 더불어 공공시설의 방역에 중요한 요소로 인식
되고 있다. 박테리아는 표면에 쉽게 부착되고 지수함수적으로 빠르게 증식하여 박테리아 군 집체를 형성한다. 따라서 바이오 필름 형성을 사전에 억제하는 기술의 중요성이 높아지고 있으며 항균성 기능을 갖는 각종 표면처리 기술을 위한 연구가 활발히 진행되고 있다.1
바이오 필름 형성을 방지하는 유효한 방법은 기질 표면에 항균제를 고정하거나 도포하는 것이다. 기존의 항균제의 경우, 분말이나 액체 형태가 주로 사용되었고 항균제 역할을 하는 물질을 고분자에 혼합하는 단순한 방법을 사용하는데, 시간이 지남에 따라 고분자로부터 서서히 용출되어 결국은 모두 제거된다. 이는 항균 성능 지속성의 문제를 야기한다.
아미노산으로 구성된 항균 펩타이드는 세포막에 구멍을 내어 파괴하는 특이한 작용기작으로 주목을 받아왔으며, 화학적 기법을 통해 생체재료 표면에 고정시켜 병원균의 표면 부착을 억제할 수 있다. 하지만 인간 세포에도 독성을 갖는 문제점으로 인해 펩타이드의 항균 작용기를 가진 합성 고분자 화합물에 대한 연구들이 진행 중에 있으며,2-4 대두 껍질로부터 추출한 폐기물 셀룰로오스를 3-aminopropyl triethoxysilane(APTES)으로 기능화하여 항균 특성을 부여한 연구도 확인되었다.5
실란계 코팅 막은 조밀한 무기계 실리카 그물 구조를 형성함으로써 내구성의 비약적 증가와 밀도 증가로 인한 오염물의 침투를 방지하며, 작용기의 2차원적 배열로 인한 표면적의 증대에 따른 항균성의 극대화라는 특징을 갖는다.6 따라서 기존의 항균성 고분자 막이 가지는 문제점들을(예: 향균제의 용출, 단시간 내에 확산 및 오염으로 인한 향균성의 심각한 저하 등)을 해결할 수 있다.7
본 연구에서는 항균력 지속을 극대화 하기 위해 표면에 아민 작용기를 가지는 유-무기 복합성 실란 박막을 고밀도로 배열시키는 방법을 제시하였다. 특히 친수성 알콕시 작용기가 기판 측과 실란 네트워크를 형성함으로써 아민 또는 아민 염 작용기를 표면 측으로 배향시킬 수 있다. 양이온화된 아미노기(NH3+)와 같이 양이온을 함유하는 항균성 작용기는 음이온 성인 세균의 세포막과 정전기적으로 결합하여 파괴하고 성장을 억제시킨다. 따라서 표면 측으로 배향되는 아미노기의 수를 제어할 수 있다면, 제조된 필름의 항균성을 극대화할 수 있을 거라 기대된다.8-10
에톡시 그룹의 수가 다른 아미노실란계 시약인 APTES, 3-aminopropyl(diethoxy) methyl silane(APDEMS), 3-amino propyl dimethyl ethoxy silane(APDMES)으로 제조한 용액을 각각 polydimethylsiloxane(PDMS) 기판 위에 코팅하여 기능화된 항균 필름을 제조하였다. 제조된 각 필름의 항균성 여부를 조사하고 아미노실란계 시약의 종류에 따른 특성을 Fourier transform infrared(FTIR), X-ray photoelectron spectroscopy(XPS), 접촉 각 측정 및 thermogravimetric analysis(TGA)를 통해 확인하고 고찰하였다.
시약 및 재료. 본 실험을 위해 polydimethylsiloxane(PDMS; SYLGARD 184, Sigma Aldrich, 미국), hydroxyl-terminated polydimethylsiloxane(PDMS; Sigma Aldrich, 미국)을 사용하였고 캐빈 필터는 일반적으로 자동차용 에어컨 필터로 사용되는 폴리프로필렌 필터를 사용하였다. 항균 용액 제조에 사용된 아민기를 기능화시킬 실란 커플링제(silane coupling agents)로 APTES(Sigma Aldrich, 미국), APDEMS(Sigma Aldrich, 미국)와 APDMES(Gelest, 미국)을 구매하여 사용하였다.
항균 용액의 제조. 본 연구에서는 아민 작용기를 갖는 아미노실란계 시약 APTES, APDEMS, APDMES 3종류를 준비하였다. 각각의 시약들과 증류수의 2:1의 비율로 넣고 1시간 동안 가수분해시킨 후 에탄올을 증류수와 1:10의 비율로 넣고 70 oC에서 4시간 동안 용해시켜 항균용액을 제조하였다.
항균코팅용액을 이용한 코팅 필름의 제조. 먼저 SYLGARD 184를 사용해 pre-cured PDMS 용액을 유리 기판에 올린 후, 200 rpm으로 스핀코팅을 진행하였다. 코팅 후 PDMS를 60 oC 오븐에서 약 3시간 동안 경화시켜 PDMS 필름을 제작하였다. 코팅용액과의 결합을 위해 경화된 PDMS 필름 표면층에 O2 플라즈마 처리를 하였다. 준비된 아미노실란계 시약, 물, 에탄올을 2:1:10 비율로 합성한 코팅 용액을 O2 플라즈마 처리된 PDMS 필름 위에 올려 스핀 코팅한 후, 60 oC 오븐에서 건조시켰다. 유리 기판과 항균용액이 코팅된 PDMS 필름을 분리하여 최종적으로 PDMS-아미노실란 항균 코팅 필름을 얻을 수 있었다.
항균코팅용액을 이용한 코팅 필터의 제조. 증류수로 세척 후 건조시킨 폴리프로필렌 필터를 준비하였다. 필터를 12 wt% hydroxyl-terminated PDMS 용액에 침지시켜 딥-코팅하고 60 oC에서 건조하였다. PDMS가 코팅된 필터를 준비된 세 가지 항균 코팅 용액에 각각 침지시켜 딥-코팅하였다. 코팅된 필터를 60 oC 오븐에서 건조시켜 최종적으로 PDMS-아미노실란 항균 코팅 필터를 얻을 수 있었다. Figure 1에 아미노실란을 사용한 항균 코팅 필름과 필터의 제조 절차를 나타내었으며 Figure 2는 최종적으로 제작된 유-무기 실란박막의 화학적 구조와 PDMS 표면과의 결합을 나타내는 도표이다.
항균 특성 평가. PDMS 위 APTES, APDMES, APDEMS를 코팅한 3개의 필름과 비교를 위해 아무런 코팅도 하지 않은 PDMS 기판 1개를 포함한 총 4개의 필름을 준비하고 캐빈 필터 위에 PDMS를 코팅한 후 APTES, APDMES, APDEMS를 코팅한 필터들을 이용하여 항균성 시험을 진행하였다. 필터의 항균성 시험은 KS K 0693 시험법의 규격에 따라 포도상구균(ATCC 6538)과 폐렴간균(ATCC 4352)의 두 균주를 사용하였고, 필름의 항균성 분석의 경우에는 JIS 2801-2010 필름밀착법으로 포도상구균(ATCC 6538)과 대장균(ATCC 8739)의 두 균주를 배양 후 균 수를 측정하였다.
화학 구조 분석. 아미노실란 시약 세 종류로 코팅한 PDMS 필름의 화학구조를 알아보기 위하여 적외선 분광 분석기(INVENIO X, Hyperion 2000 Bruker, USA)를 사용하여 질소 분위기하에서 측정하였다. 파장 범위는 4000-600 cm-1이고, 반사법(ATR method)에 의하여 화학구조를 확인하였다. 또한, 필름 표면의 조성 및 화학적 결합 상태를 확인하기 위해 X-선 광전자 분광기(Versaprobe III, ULVAC-PHI, Japan)를 사용하였다. XPS 스펙트럼에서 결합 에너지는 284.6 eV의 탄소(C1s)를 기준으로 보정되었다.
열적 특성 분석. 시약 종류에 따른 열분해 거동을 확인하기 위하여 열중량분석기 500(Auto-TGA Q500, TA Instruments, USA)를 사용하여 측정하였다. 분석은 질소 분위기 하에서 승온 속도 10 oC/min으로 30 oC부터 700 oC까지의 시료의 중량 감소 변화를 측정하였다.
접촉각 분석. 항균 코팅 필름의 물리적 특성 변화를 확인하고 친수성을 알아보기 위하여 접촉각 기기(contact angle system DSA100, KRUSS, Germany)를 사용하여 측정하였다. 접촉각 측정은 일정한 양의 증류수를 필름 표면 위에 떨어뜨린 후 측정하였으며 기기에 부착되어 있는 디지털 카메라를 이용하여 사진으로 촬영하여 결과를 평가하였다. 접촉각은 물방울이 떨어지고 30초가 지났을 때의 값을 측정하였으며, 동일한 시료를 3회 반복 측정하여 비교하였다.
표면 및 원소 분석. 두께측정기(Alpha-step 500, KLA-Tencor, USA)를 이용해 코팅 막 두께를 측정하였고 항균 코팅 필름의 구성되어 있는 원소들의 정량 분석을 조사하기 위하여 항균성 필름의 표면을 energy dispersive spectroscopy(EDS; SNE-3000MS, SEC, Korea)를 이용하여 측정하였다

|
Figure 1 Experimental procedure for preparation of hybrid aminosilanes coating films on glass plate. |

|
Figure 2 Chemical structures and diagrams representing surface bonding with PDMS treated O2 plasma: (a) APTES may form Si– O–Si bonds to other APTES molecules, resulting in formation of a thick disordered surface layer; (b) APDEMS is less likely to oligomerize, forming a more uniform surface layer; (c) APDMES is unable to oligomerize and may only form a surface monolayer. |
항균 특성 평가. 코팅 층 표면의 정균 및 살균 특성을 확인하기 위해 Staphylococcus aureus(ATCC 6538P)와 Escherichia coli(ATCC 8739) 두 균종에 대한 항균력 시험(JIS Z 2801-2010)을 실시하여 필름 표면에서의 항균 및 균의 증식 억제 효과를 실험하였다. Figure 3와 Table 1은 PDMS 기판 위에 APTES, APDEMS APDMES를 각각 코팅한 필름과 아무런 코팅을 하지 않은 PDMS기판의 항균성 실험 결과 사진 및 표이다. 항균 용액을 코팅한 필름들은 황색 포도상 구균(S.aureus)과 대장균(E.coli)의 모든 경우에서 99.9%의 항균성을 보이며, 항균 활성치 값은 4.8이다. 이는 아무런 항균 코팅을 하지 않은 Bare PDMS의 항균 활성치인 2.3과 비교하였을 때, 두배 이상의 항균 활성치를 나타냈다. Table 2는 APTES와 APDEMS로 만든 항균용액을 코팅한 pp필터의 항균성 시험 결과이다. 대장균과 폐렴균에서 모두 99.9%의 항균성을 보여준다.
JIS Z 2801 규격에 따라 항균성 99.9%, 활성치 2.0 이상의 수준에서 항균성을 부여 받으므로,10 포도상구균, 대장균을 사용한 본 실험에서 제작된 항균 코팅 필름의 항균 활성치가 4.8로 우수한 항균효과를 갖는 것을 확인하였다.또한 KS K 0693에 따른 항균성 99.9%의 결과에 따라 필터에 코팅을 하여도 항균성이 유지됨을 확인하였다.
화학 구조 특성. PDMS 표면에 항균 용액을 코팅한 필름의 화학 구조적 특성을 확인하기 위하여 적외선 분광 분석법을 사용하였다. 그 결과 Figure 4와 같은 스펙트럼을 얻을 수 있었다. FTIR 측정 결과, APTES, APDEMS, APDMES 용액을 코팅한 PDMS 필름들의 그래프 거동은 비슷하게 나타났다. PDMS의 고유피크로써 790 cm-1 에서 메틸 그룹의 C-H 신축 진동 피크,11 842 cm-1에서 Si-O 신축 진동,12 884 cm-1 에서 보여주는 약 800 cm-1의 Si-C 신축 진동은 s-결합된 Si-C매트릭스의 존재를 나타낸다.13 Figure 4의 (a)에서 1010 cm-1 부근의 Si-O-Si 피크와 비교해 상대적으로 790 cm-1 부근의 C-H 피크가 크게 나타났다. 이는 산소 플라즈마 처리를 하지 않은 PDMS 표면이기 때문이다. 1060 cm-1과 1010.64 cm-1 부근의 강한 밴드는 실록산 구조와 관련된 Si-O-Si 신축 진동이며14 3300-3500 cm-1에서 아민 그룹의 N-H 신축 진동, 2900-3000 cm-1의 범위에서 알킬기의 메틸 그룹 C-H 신축 진동을 확인하였다.15 이는 아미노실란을 코팅하지 않은 PDMS에는 나타나지 않은 피크이며 PDMS 표면에 아미노실란이 잘 부착되었음을 보여준다. 또한 Si-O-Si 피크와 N-H 피크의 상대 크기를 비교하였을 때 APDEMS가 가장 표면 방향으로 아민기의 배향이 잘 되어있음을 확인할 수 있다.
Figure 5는 APTES, APDEMS, APDMES를 코팅한 PDMS 표면의 survey scan mode의 XPS 스펙트럼과 narrow scan mode의 C1s, O1s, Si2p, N1s 피크를 각 구성 성분에 의한 피크로 분리한 결과를 나타낸 것이다. 고 해상도 N1s 피크에서 401.38 eV(protonated amine, NH3+), 400.5 eV(-R2 NH, O-CO-N), 399.87 eV(-N-CO-N-), 399.2 eV(-R-NH2), 398.2 eV(C-N), and 397.5 eV(N-Si)의 서브 피크들로 분리됐다.16 각 피크들은 아민 작용기가 PDMS 표면에 성공적으로 결합했음을 보여준다. C1s 피크는 283.5 eV(C-Si), 284.6 eV(-C=C- 혹은 –C-C), 285 eV(C-H 혹은 C-C), 285.8 eV(C-N 혹은 C-N+), 286.9 eV (C-O)로 분리되었다. C-N/C-N+ 피크 또한 아미노실란 층의 형성을 확인했다.17-19 Si 2p 피크에서는 101.9 eV(Si-organic), 102 eV(silicon SiO2), 103 eV(SiO2)에 해당되는 결합에너지로 분리되는 것을 보여준다.20-22
PDMS-APTES, PDMS-APDEMS, PDMS-APDMES의 N1s / Si2p intensity ratio는 각각 0.549, 0.893, 0.031의 값을 가지고 Table 3의 atomic ratio 또한 0.9658, 0.9823, 0.4783을 보여준다. 표면 측 아민 작용기의 배열 정도는 N1s피크와 C1s피크의 강도 비(N1s/C1s)를 통하여 확인하였으며, 코팅 필름의 표면에 PDMS-APDEMS, PDMS-APTES, PDMS-APDMES 순으로 아민 작용기가 상대적으로 더 많이 존재함을 확인하였다.
두께 측정 및 접촉각 특성. 코팅 필름의 두께는 두께 측정기를 사용하였다(Figure S2). PDMS-APTES와 PDMS-APDEMS의 두께는 각각 1,158.3 nm와 303.81 nm이며, PDMS-APDMES의 두께는 45.746 nm이다. 이러한 결과는 APTES와 APDEMS보다 APDMES가 더 얇은 표면 필름을 형성한다는 연구 보고와 일치한다.23
Figure 6는 PDMS기판 위 각각 세 종류의 항균 용액을 코팅한 필름의 접촉 각 측정 결과이다. 접촉 각은 물방울이 떨어지고 10초가 지났을 때의 각을 측정하였다. 어떠한 처리도 하지 않은 PDMS는 소수성을 갖는다. 이에 친수성을 부여하는 표면 작용기인 아민(NH2)의 형성으로 인해 PDMS표면에 대한 소수성의 변화를 확인하였다. APDMES, APTES, APDEMS로 코팅한 PDMS 필름들의 평균 접촉각은 각각 96.41o, 103.163o, 107.407o로 나타났다. 접촉각이 작은 순서는 Table 3의 N1s/Si2p ratio가 큰 순서와 같으며, PDMS 표면방향으로 아민 작용기가 잘 배향되어 있음을 확인했다.
열적 특성. Figure 7에 PDMS-APTES, PDMS-APDMES, PDMS-APDEMS 필름의 TGA 측정결과를 나타내었다. 110- 140 oC 온도범위에서 초기 열분해가 나타난 것을 확인하였다. APDEMS는 최대 열분해가 발생하기까지 열분해가 급격히 진행되는 것에 비하여 APTES와 APDMES는 비교적 서서히 진행됨을 확인하였다. 350-500 oC 온도범위에서 APDEMS, APTES, APDMES 순으로 최대 열분해가 발생하는 것을 보여주었다. 700 oC 부근의 잔류 질량은 주로 Si-O-Si로 구성된 코팅의 무기 부분이며 첫 번째와 두 번째 질량 손실은 남아있는 수분과 유기 상의 손실에 기인하며, 이러한 분해 과정은 매트릭스의 해 중합 및 Si-C 결합의 단절에 기인함을 보여주었다. Sardon 등은 SiO2 네트워크가 사슬 끝 단의 기체화를 방지한다는 결과를24 보여주었다. 이는 APDEMS가 가지고 있는 두 개의 에톡시 그룹과 PDMS사이의 Si-O 결합에 의해 가장 높은 열분해 온도와 적은 질량 손실 율을 갖는다고 생각된다.25 Figure 2와 같이 APTES는 PDMS 표면에 있는 에톡시 그룹 3개가 모두 결합 기판 표면과 결합하지 않을 뿐만 아니라 자체적으로 네트워크를 형성하기 때문에26 APTES가 분해되는 과정에서 APDEMS보다 열분해가 비교적 낮은 온도에서 일어나고 에톡시 그룹이 한 개인 APDMES는 350 oC 라는 상당히 낮은 온도에서 분해되기 시작한다. 따라서 Table 3과 Table 4를 통해 PDMS 표면에 배향된 아민 작용기의 수가 많은 APDEMS, APTES, APDMES 순으로 열분해 온도와 질량 손실 율이 같은 경향을 보임을 확인할 수 있다.
|
Figure 3 Photographs of viable colonies growing on (a1,a2) Untreated test piece; (b1,b2) Bare PDMS; (c1,c2) PDMS-APTES; (d1,d2) PDMS-APDEMS; (e1,e2) PDMS-APDNES agar plates. |

|
Figure 4 FTIR spectra of (a) pristine PDMS; (b) APTES; (c) APDMES; (d) APDEMS. |

|
Figure 5 X-ray photoelectron spectroscopy (XPS) analysis: (a) full scan spectrum; (b) narrow scan of C1s; (c) N1s; (d) Si2p of (1) APTES; (2) APDMES; (3) APDEMS coating on PDMS. |

|
Figure 6 Contact angle of PDMS-APDMES, PDMS-APTES and PDMS-APDEMS. |

|
Figure 7 TGA and DTA plots and weight derivative curves: (a) APTES; (b) APDEMS; (c) APDMES. |
|
Table 1 Antibacterial Test (JIS Z 2801-2010) Results of Aminosilanes Coating Films |

U0: The average of the common logarithm of the number of viable bacteria that recovered from control sample at “0 h” contact time (6.2×103-2.5×104 cell/cm2) |
|
Table 2 Antibacterial Test (KS K 0693) Results of Aminosilanes Coated on PP Filters |

|
Table 4 TGA Parameters for Antimicrobial Solution Coating on PDMS Films |

*The residue was measured as a mass percent at 700 ℃. |
본 연구에서는 좀 더 안정화된 항균 코팅 필름을 제조하기 위해 아미노실란인 APTES, APDEMS, APDMES을 사용하여 PDMS 코팅 층 표면에 아민 작용기를 가지는 하이브리드 유-무기 실란 박막을 고밀도로 배열시켰다. 제조된 필름의 항균성을 확인하고, FTIR, TGA, XPS, 접촉 각 분석을 이용하여 필름의 특성을 조사하였다.
세 종류의 아미노 실란계를 코팅한 필름의 FTIR, XPS 분석 결과, 항균 코팅 필름에서 Si-O-Si, Si-C 피크가 나타나 표면에 실란올이 PDMS 표면에 잘 부착되어 있음과 아민, 아민 염 피크의 관찰로 PDMS 표면방향으로 아민 작용기가 배열되어 있음을 확인했다. 세 종류의 아미노 실란계 항균 용액 코팅 필름 중 PDMS-APDMES 필름에서 표면의 N/Si 상대 크기가 가장 크게 나타났으며 열 분석 그래프에서도 비슷한 거동을 보여준다. 이는 에톡시 그룹의 수가 1개, 2개, 3개 순으로 표면 측에 아민작용기가 더 많이 배향될 것이라고 예상했던 결과와 다르다. APDMES는 1개의 에톡시 그룹을 갖고 있는데, 1개의 에톡시 그룹과 PDMS 표면의 하이드록시 그룹이 결합하여 안정적으로 모노레이어를 형성한 것과 다르게 APTES와 APDEMS는 각각 2개, 3개의 에톡시 그룹들이 모두 PDMS표면에 부착되어 모노레이어를 형성한 것이 아닌 아닌 서로 결합하여 두꺼운 벌크 층이 형성되었기 때문이다. 같은 조건으로 슬라이드 글라스에 코팅한 실란 박막의 두께를 측정하여 APTES, APDEMS, APDMES 순으로 두께가 두꺼운 것을 확인할 수 있었고 그에 따라 N/Si ratio에 영향을 주었다고 예상한다 또한 PDMS-APTES, PDMS-APDEMS, PDMS-APDMES의 항균활성치는 PDMS-APDMES가 가장 낮은 N/Si ratio를 갖지만 세 종류의 아미노실란계 코팅 필름은 모두 99.9% 세균감소율과 4.8의 높은 항균활성치를 보여주었는데, APTES와 APDEMS를 SAM(Self Assembled Monolayer)로 형성할 수 있다면, 에톡시 그룹이 1개, 2개, 3개 순인 APDMES, APDEMS, APTES 순으로 아민작용기를 표면 측으로 배향시키는 상대적인 수도 많을 것이며, 배향된 작용기의 수에 따라 항균활성치 또한 같은 경향을 보일 것으로 예상된다.
이와 같은 결론으로부터 항균성이 우수한 하이브리드 유-무기 실란 박막을 제조하고 아미노실란 기능화를 통해 항균성 작용기를 고밀도로 배열시킴으로써 항균 특성을 갖는 표면 코팅을 적용한 기능성 소재를 개발하고 다양한 분야에 활용 가능할 것으로 기대한다.
- 1. Cho, W. K..; Kang, S. M.; Lee, J. K.Non-Biofouling Polymeric Thin Films on Solid Substrates. J. Nano Sci. Nano Technol. 2014, 14, 1231-1252.
-

- 2. Kim, J. E.; Park, J. P. Recent Advances in Pathogenic Bacteria Detection with Antimicrobial Peptide as Recognition Element. KSBB J. 2022, 37, 83-92.
-

- 3. Zhu, M.-M.; Fang, Y.; Chen, Y.-Y.; Lei, Y.-Q.; Fang, L.-F.; Zhu, B.-K.; Matsuyama, H. Antifouling and Antibacterial Behavior of Membranes Containing Quaternary Ammonium and Zwitterionic Polymers. J. Colloid Interface Sci. 2021, 584, 225-235.
-

- 4. Saverina, E. A.; Frolov, N. A.; Kamanina, O.A.; Arlyapov, V. A.; Vereshchagin, A. N.; Ananikov, V. P. From Antibacterial to Antibiofilm Targeting: An Emerging Paradigm Shift in the Development of Quaternary Ammonium Compounds (QACs). ACS Infect. Dis. 2023, 9, 394-422.
-

- 5. Tummino, M. L.; Laurenti, E.; Bracco, P.; Cecone, C.; Parola, V. L.; Vineis, C.; Testa, M. L. Antibacterial Properties of Functionalized Cellulose Extracted from Deproteinized Soybean Hulls. Cellulose. 2023, 30, 7805-7824.
-

- 6. Yoo, S. H.; Song, H. J.; Kim, C. K. Surface Treatment of Silica Nanoparticles and the Characteristics of Their Composites with Thermoplastic Polyurethane Elastomer. Polym. Korea. 2012, 36, 721-726.
-

- 7. Vázquez, M.; Velazquez G.; Cazón, P. UV-Shielding Films of Bacterial Cellulose with Glycerol and Chitosan. Part 2: Structure, Water Vapor Permeability, Spectral and Thermal Properties. J. Food Sci. 2021, 19, 115-126.
-

- 8. Ko, S.; Lee, J.-Y.; Park, D. S. Recent Progress of Antibacterial Coatings on Solid Substrates Through Antifouling Polymers. J. Appl. Chem. Eng. 2021, 32, 371-378.
- 9. Baik, S. Y.; Park, Y. J.; Choi, S. H.; Kim, H. J.; Kim, S. T. Effect of Quaternary Ammonium Compounds on Microbial Contamination Levels in Dental Clinics. J Dent Rehabil Appl Sci. 2020, 36, 55-60.
-

- 10. Kim, U. S.; Choi, J. H.; No, H. G.; Han, K. S.; Kim, J. H.; Hwang, K. T. Antibacterial Properties of Traditional Ceramic Glazes Containing Copper Oxide. J. Korean Cryst. Growth Cryst. Technol. 2019, 29, 372-378.
-

- 11. Kılıç, E. C.; Salt, Y. Preparation and Characterization of Polydimethylsiloxane-based Composite Films.Mater. Test. 2021,63, 984-987.
-

- 12. Plymale, N. T.; Kim, Y.-G.; Soriaga, M. P.; Brunschwig, B. S.; Lewis, N. S. Synthesis, Characterization, and Reactivity of Ethynyl- and Propynyl-Terminated Si(111) Surfaces. J. Phys. Chem. C. 2015, 119, 19847-19862.
-

- 13. Cesare, G. D.; Galluzzi, F.; Guattari, G.; Leo, G.; Vincenzoni, R.; Bemporad, E. Structural, Optical and Electronic Properties of Wide Band Gap Amorphous Carbon-Silicon Alloys. Diam. Relat. Mater. 1993, 2, 773-777.
- 14. Jeronimo, K.; Koutsos, V.; Cheung, R.; Mastropaolo, E. PDMS-ZnO Piezoelectric Nanocomposites for Pressure Sensors. J. Sensors. 2021, 21, 5873.
-

- 15. Dai, Z.; Deng, J.; Ansaloni, L.; Janakiram, S.; Deng, L. Thin-film-composite Hollow Fiber Membranes Containing Amino Acid Salts as Mobile Carriers for CO2 Separation. J. Membr. Sci. 2019, 578, 61-68.
-

- 16. Šetka, M.; Calavia, R.; Vojkůvka, L.; Llobet, E.; Drbohlavová J.; Vallejos, S. Raman and XPS Studies of Ammonia Sensitive Polypyrrole Nanorods and Nanoparticles. Sci. Rep. 2019, 9, 8465.
-

- 17. Truica-Marasescu, F.; Wertheimer, M. R. Wertheimer. Nitrogen-Rich Plasma-Polymer Films for Biomedical Applications. Plasma Process Polym. 2008, 5, 44-57.
-

- 18. Chen, Z.; Pronkin, S.; Fellinger, T.-P.; Kailasam, K.; Vilé, G.; Albani, D.; Krumeich, F.; Leary, R.; Barnard, J.; Thomas, J. M; Pérez-Ramírez, J.; Antonietti, M.; Dontsova, D. Single-Atom-Dispersed Silver and Carbon Nitride to a Joint Electronic System via Copolymerization with Silver Tricyanomethanide. ACS Nano. 2016, 10, 3166-3175.
-

- 19. Nourmohammadi, J.; Hajibabaei, T.; Amoabediny G.; Jafari, S.; Salehi-Nik, N. Aminosilane Layer Formation Inside the PDMS Tubes Improves Wettability and Cytocompatibility of Human Endothelial Cells. Trends Biomater. Artif. Organs. 2015, 29, 123-131.
- 20. Huang, J.; Ding, S.; Xiao, W.; Peng, Y.; Deng, S.; Zhang, N. 3-Aminopropyl-triethoxysilane Functionalized Graphene Oxide: A Highly Efficient and Recyclable Catalyst for Knoevenagel Condensation. Catal. Lett. 2015, 145, 1000-1007.
-

- 21. Chowdury, M. S. K.; Cho, Y. J.; Park, S. B.; Park, Y.-I. Nanohybrid Graphene Oxide Membranes Functionalized using 3-mercaptopropyl trimethoxysilane for Proton Exchange Membrane Fuel Cells. J. Membr. Sci. 2022, 663, 121035.
-

- 22. Cho, Y. J.; Chowdury, M. S. K.; Park, Y. J.; Jeong, S. M.; Park, S. B.; Park, Y.-I. Fabrication of Hydrogen-Permeable Ni-Zr Thin Films for Efficient Hydrogen Separation and Their Application in Graphene Oxide-Hydrogen Membrane Fuel Cells. J. Phys. Chem. C, 2023, 127, 22897-22910.
-

- 23. Moon, J.; Kim, J. H.; Kim, K.-J.; Kang, T.; Kim, B.; Kim, C.-H.; Hahn, J.; Park, J. W. Absolute Surface Density of the Amine Group of the Aminosilylated Thin Layers: Ultraviolet-Visible Spectroscopy, Second Harmonic Generation, and Synchrotron-Radiation Photoelectron Spectroscopy Study. Langmuir. 1997, 13, 4305-4310.
-

- 24. Sardon, H.; Irusta, L.; Santamaría, P.; Fernández-Berridi, M. J. Thermal and Mechanical Behaviour of Self-curable Waterborne Hybrid Polyurethanes Functionalized with (3-Aminopropyl)triethoxysilane (APTES). J Polym Res. 2012, 19, 9956.
-

- 25. Sun, Y.; Yanagisawa, M.; Kunimoto, M.; Nakamura, M.; Homma, T. Depth Profiling of APTES Self-Assembled Monolayers Using Surface-Enhanced Confocal Raman Microspectroscopy. Spectrochim. Acta - A: Mol. Biomol. Spectrosc. 2017, 184, 1-6.
-

- 26. Larsen, B. A.; Hurst, K. M.; Ashurst, W. R. Mono and Dialkoxysilane Surface Modification of Superparamagnetic Iron Oxide Nanoparticles for Application as Magnetic Resonace Imaging Contrast Agents. J. Mater. Res. 2012, 27, 1846-1852.
-

- Polymer(Korea) 폴리머
- Frequency : Bimonthly(odd)
ISSN 0379-153X(Print)
ISSN 2234-8077(Online)
Abbr. Polym. Korea - 2025 Impact Factor : 1.0
- Indexed in SCIE
 This Article
This Article
-
2024; 48(3): 274-281
Published online May 25, 2024
- 10.7317/pk.2024.48.3.274
- Received on Nov 21, 2023
- Revised on Jan 8, 2024
- Accepted on Feb 20, 2024
 Services
Services
Shared
 Correspondence to
Correspondence to
- Yong-il Park
-
School of Materials Science and Engineering, Kumoh National Institute of Technology, 61 Daehak-ro, Gumi, Gyeongbuk 39177, Korea
- E-mail: ebml7743@gmail.com
- ORCID:
0000-0002-7469-5031









 Copyright(c) The Polymer Society of Korea. All right reserved.
Copyright(c) The Polymer Society of Korea. All right reserved.